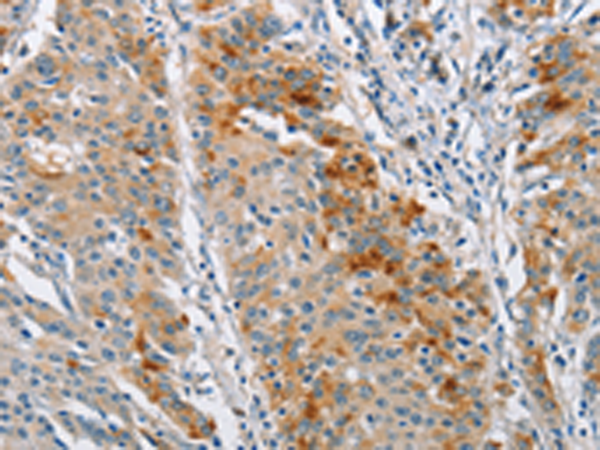

-
分类: 科研抗体货号: P08065别名: CLAP; mE10; CIPER; c-E10; CARMEN应用: WB,IHC反应种属: Human, Mouse, Rat
-
分类: 科研抗体货号: P08067别名: BDH; SDR9C1应用: IHC反应种属: Human, Mouse, Rat
-
分类: 科研抗体货号: P08083别名: BS69; BRAM1; MRD30应用: WB,IHC反应种属: Human, Mouse
-
分类: 科研抗体货号: P08064别名: BCAM; BCT2; PP18; BCATM应用: WB,IHC反应种属: Human, Mouse, Rat
-
分类: 科研抗体货号: P08082别名: BRK应用: IHC反应种属: Human, Mouse
-
分类: 科研抗体货号: P08063别名: DAM1; SPF27; Snt309应用: WB,IHC反应种属: Human, Mouse
-
分类: 科研抗体货号: P08081别名: NNE; PPH; MPB1; ENO1L1应用: WB,IHC反应种属: Human, Mouse, Rat
-
分类: 科研抗体货号: P08062别名: CDM; BAP31; 6C6-AG; DXS1357E应用: WB,IHC反应种属: Human, Mouse
-
分类: 科研抗体货号: P08080别名: 4EBP2; PHASII应用: IHC反应种属: Human, Mouse
-
分类: 科研抗体货号: P08061别名: BAT; BACAT应用: WB,IHC反应种属: Human

鄂公网安备42018502007531号
鄂公网安备42018502007531号

